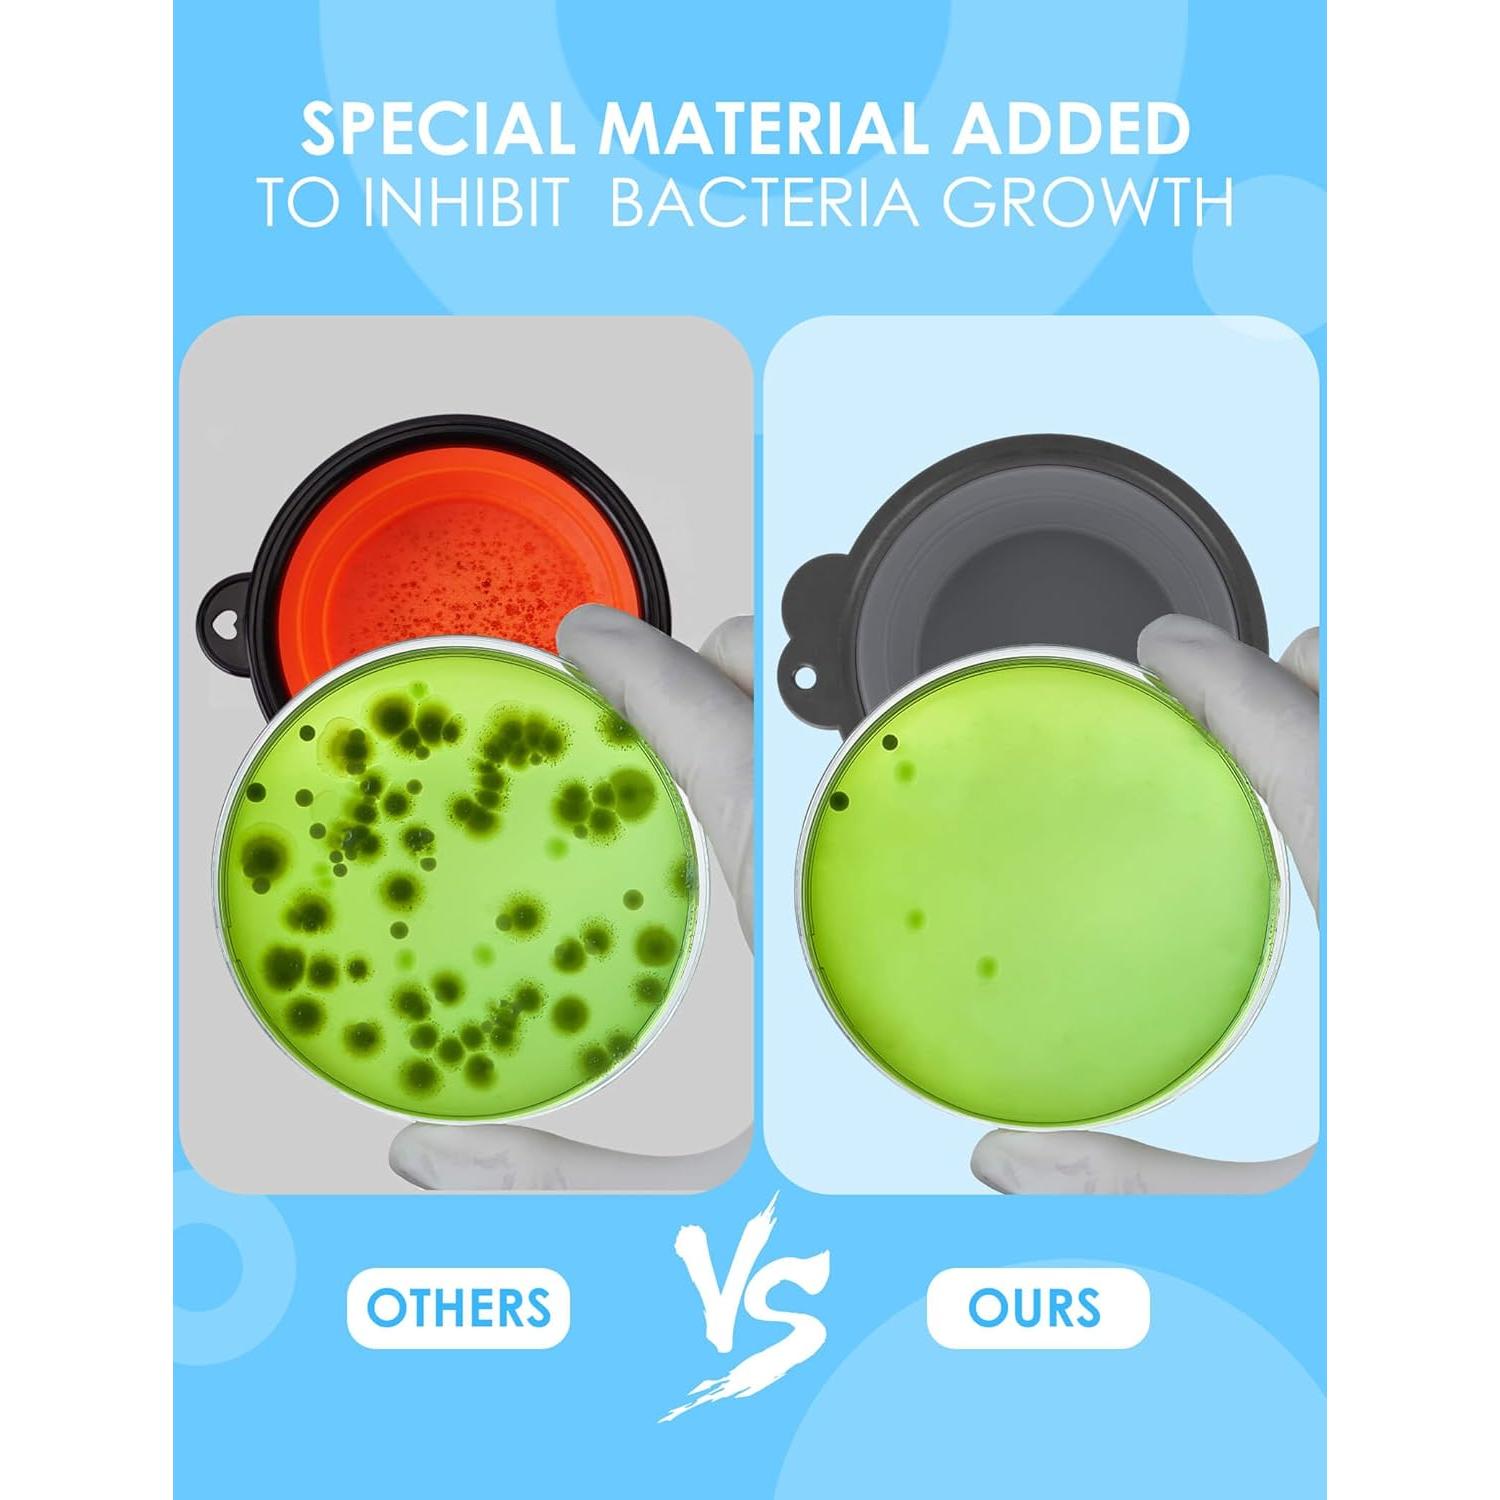
Cuencos Plegables para Perros Aonkey - 2 Piezas 425ml

Outward Hound
Cuencos Plegables para Perros Aonkey - 2 Piezas 425ml

1.000+ vendidos
Cuencos Plegables para Perros Aonkey - 2 Piezas 425ml
$35.371
+ impuestos: $7.428
Llega a domicilio entre el 31 de ene y el 5 de feb
- Compra protegida
- Envío a todo el país
- Garantía de entrega
Características destacadas
- 【Único y Diferente】El set de cuencos para perros Aonkey está en una liga propia, abordando problemas a partir de comentarios sobre otros cuencos. El carabinero mejorado cuenta con una apertura más grande y resistente, reduciendo el riesgo de rotura. Además, disfruta de la comodidad añadida de los portabotellas, compatibles con la mayoría de las botellas de agua en forma de cola del mercado.
- 【Estructura Revolucionaria】Di adiós a la molestia de los anillos de plástico ensamblados. El cuenco plegable para perros de Aonkey cuenta con una estructura mejorada, integrando silicona suave con un borde duro. No más preocupaciones sobre el anillo que se salga o se rompa, y el agujero del clip permanece intacto.
- 【Estabilidad Inigualable】Gracias al borde duro integrado, nuestro cuenco para perros se mantiene firme cuando está desplegado. No más derrames ni pérdida de estructura. Llévalo con confianza con una mano, incluso cuando está lleno de agua.
- 【Perfecto para Llevar】Estos cuencos de viaje son muy fáciles de empacar ya que se colapsan sin esfuerzo. Sujétalos a una mochila o botella de agua - ideal para salir al parque, hacer senderismo, conducir o cualquier actividad social con tu amigo peludo.
- 【Seguridad Primero】Fabricado con silicona de alta calidad, apta para alimentos y con un tentador sabor a carne, nuestro cuenco plegable para perros elimina el típico olor a silicona que a los perros no les gusta. Libre de BPA, apto para lavavajillas, no solo es conveniente sino también saludable para tu mascota.
Opiniones de compradores
1.333 opiniones
Cathie
Este artículo se ve tal como en la imagen. Tengo dos yorkies y necesito cuencos para viajar. Debería haber elegido el tamaño grande para los dos, pero eso es culpa mía y no del producto. Funcionarán muy bien para nuestras noches y viajes por carretera. Tamaño perfecto para un perro pequeño individual, pero recomiendo el tamaño más grande si tienes dos perros pequeños. El material de silicona parece lo suficientemente fácil de limpiar, solo los lavé y están listos para usar. Parecen muy resistent
Chels Ann
fácil de llevar en paseos y funciona genial para nuestro perro. Retiene bien el agua y fue un gran precio por dos tazones. No se necesita ensamblaje, pero el tazón se expande fácilmente cuando está plano. Gran diseño.
Wolfgirl
¡Estos tazones funcionan genial! Llevamos a nuestros dálmatas a caminar por el bosque a menudo y es agradable poder enganchar el tazón en una mochila y darles agua en cualquier momento. Se pliegan muy bien.
Ramon Lugo
Estos tazones de plástico para perros son una opción conveniente y asequible para el uso diario. Son livianos, fáciles de limpiar y vienen en una variedad de tamaños y colores para adaptarse a cualquier perro. El material es lo suficientemente duradero para la alimentación regular y se mantiene bien con el tiempo.
Sharolyn Evans
El tazón parece fácil de usar, pero no puedo convencer a mi perro mayor de que beba de él. El anillo para sostener una botella de agua no es lo suficientemente fuerte como para evitar que una botella llena se caiga.
Especificaciones técnicas
- Fabricante
- Aonkey Direct
- País de origen
- China
- Dimensiones del producto
- 14 x 12.7 x 5.1 centímetros; 132 gramos
- Número de modelo del artículo
- CDWB-806030
Preguntas y respuestas
Tu pregunta fue enviada. Te responderemos pronto.
¿Dónde te enviamos la respuesta?
Tus preguntas
· Recibirás la respuesta a
Productos relacionados
Amazon Basics
Set de 2 Tazones de Acero Inoxidable Antideslizantes Amazon Basics
Loving Pets
Cuenco Antideslizante para Perros y Gatos Loving Pets 17cm Arándano
Loving Pets






